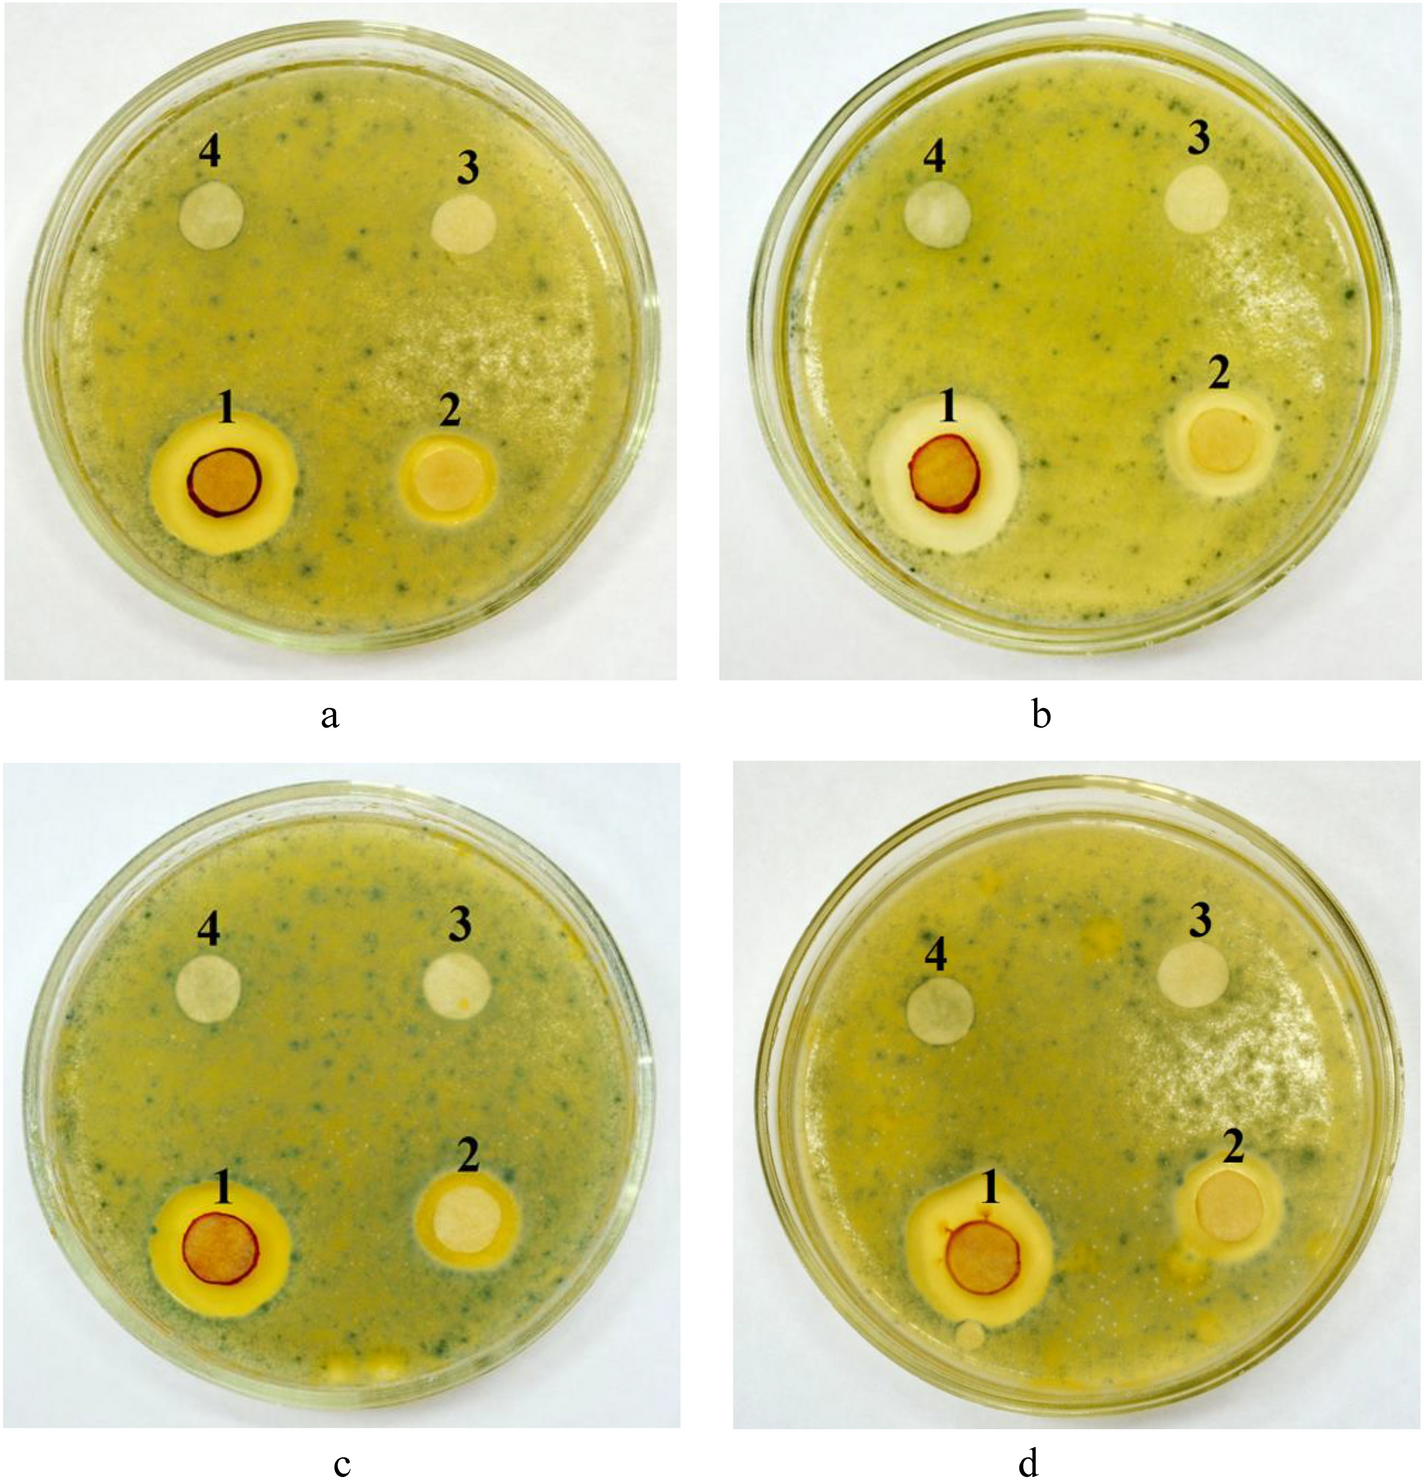
Fig. 9

Fig. 9
Investigation of the effect of concentration of disinfectant component—Ag NPs-DDAB (1—0.5 mg/mL, 2—0.05 mg/mL, 3—0.005 mg/mL, 4—0.0005 mg/mL) and type of detergent base (a) tap water, (b) cheese WM, (c) curd WM, (d) casein WM) on Penicillium roqueforti.
